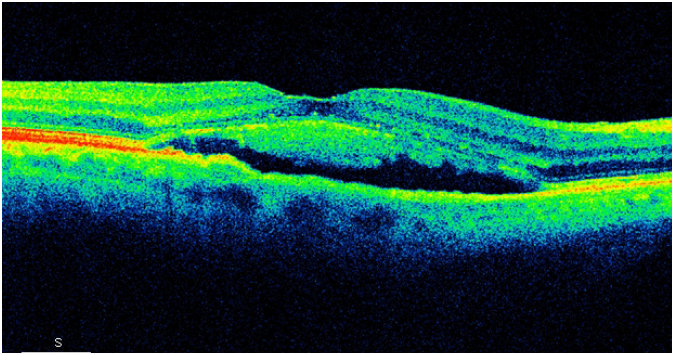
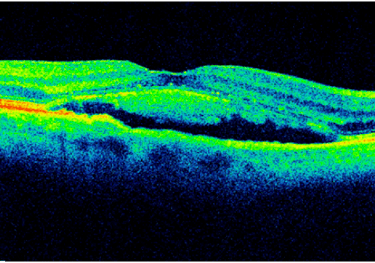

Choroby siatkówki
Baza wiedzy
Przydatne informacje dla lekarzy okulistów.
Centralna surowicza chorioretinopatia (CSCR) – aktualny stan wiedzy i opcje terapeutyczne
Maciej Gawęcki, Izabella Karska-Basta
Zapalny obrzęk plamki
W przygotowaniu
Dystrofie siatkówki
W przygotowaniu
Program lekowy AMD
W przygotowaniu
Program lekowy DME
W przygotowaniu
Program lekowy ZBN
W przygotowaniu
Optymalizacja leczenia RVO
W przygotowaniu
O czym trzeba pamiętać w diagnostyce RVO
W przygotowaniu
AMD - aktualne poglądy na suplementację
W przygotowaniu